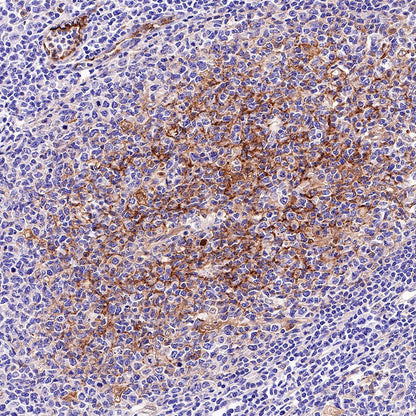
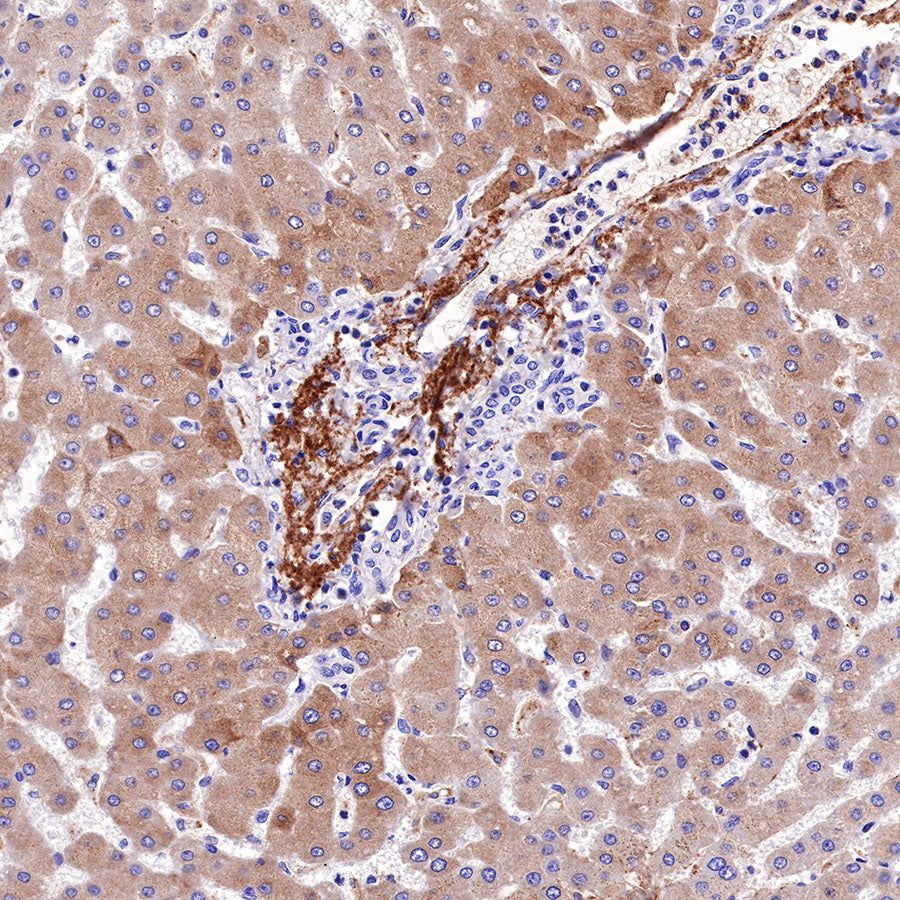

Product Specification
| Host |
Rabbit |
| Antigen |
C4d |
| Synonyms |
N/A |
| Immunogen |
Synthetic Peptide |
| Location |
Secreted |
| Accession |
P0C0L4 |
| Clone Number |
SDT-330-2 |
| Antibody Type |
Recombinant mAb |
| Application |
WB, IHC-P |
| Reactivity |
Hu |
| Purification |
Protein A |
| Concentration |
0.125 mg/ml |
| Physical Appearance |
Liquid |
| Storage Buffer |
PBS, 40% Glycerol, 0.05% BSA, 0.03% Proclin 300 |
| Stability & Storage |
12 months from date of receipt / reconstitution, -20 °C as supplied |
Dilution
| application |
dilution |
species |
| WB |
1:2500 |
|
| IHC-P |
1:1000 |
|
Background
Complement component 4 (C4), in humans, is a protein involved in the intricate complement system, originating from the human leukocyte antigen (HLA) system. It serves a number of critical functions in immunity, tolerance, and autoimmunity with the other numerous components. Furthermore, it is a crucial factor in connecting the recognition pathways of the overall system instigated by antibody-antigen (Ab-Ag) complexes to the other effector proteins of the innate immune response.C4d is a degradation product of complement activator. If C4d is high in the tumor of patients, its survival period will be reduced; Complement fragment C4d can be used as a biomarker for early diagnosis and prognosis prediction of lung cancer patients.